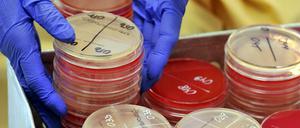
Hartnäckig. Klebsiellen sind nicht nur schwer behandelbar. Sie überleben auch besonders gut auf Oberflächen.

Liam Condon, Leiter der Agrarsparte von Bayer, über die Bedeutung von Donald Trump, die Fusion mit Monsanto und die Zukunft der Landwirtschaft.

Liam Condon, Leiter der Agrarsparte von Bayer, über die Bedeutung von Donald Trump, die Fusion mit Monsanto und die Zukunft der Landwirtschaft.

Herthas Per Skjelbred über die Lehren aus verpatzten Rückrunden, Schlägereien in der Disco von Trondheim und das Love und Peace vom Hippie-Vater.

Seine Fußspuren sind auch nach vier Jahrzehnten noch auf dem Mond zu erkennen. Nun ist Eugene Cernan im Alter von 82 Jahren verstorben.

Die Hoffnung auf Jeans, Schallplatten und einen Besuch im Thermalbad: Reise ins gelobte Land der Achtziger.
Eine US-Amerikanerin brach sich in Indien ihr Bein, die Wunde infizierte sich. Der Keim war gegen alle in den USA erhältlichen Antibiotika resistent. Niemand konnte ihr helfen.

Die ARD-Serie "WaPo Bodensee" bedient den ungebrochenen Bedarf nach leichter Vorabendkost

Die ARD-Serie "WaPo Bodensee" bedient den ungebrochenen Bedarf nach leichter Vorabendkost
An der Nuthe haben Biber mehrere Bäume gefällt. Der Grund dafür ist simpel. Auch an anderen Orten in Potsdam gab es Probleme mit Bibern, von einer Biberplage spricht die Stadt allerdings nicht.
80 US-Soldaten haben in der Nacht zum Mittwoch in Brück Station gemacht. Sie waren nicht die letzten.

Derzeit verlegen die US-Armee über Brandenburg Truppen, Last- und Geländewagen nach Polen. In der Landespolitik sorgt die US-operation für heftige Debatten. Litauens Botschafter reagiert irritiert.

Riesenschildkröten erreichten vor Jahrmillionen die Bahamas und die Galapagos-Inseln. Das zeigt das Erbgut einer vor 850 Jahren ausgestorbenen Art.

Tanze mit mir in den Morgen: Ryan Gosling und Emma Stone beschwören in „La La Land“ die goldene Ära des Hollywood-Musicals.

Präzision ist nicht immer optimale Strategie im Kampf gegen Krebs, sagt der Onkologe Ross Cagan. Er sucht mithilfe von Taufliegen nach der bestmöglichen Behandlung.

Die Hand- und Fußabdrücke, zu denen tibetische Gläubige pilgern, hinterließen Jahrtausende zuvor Steinzeitmenschen im Kalkstein.

Es ist der angeblich größte Transport des US-Militärs nach Europa seit Ende der Sowjetunion. Brandenburgs Minister Woidke ist besorgt über das Bild, das die US-Panzer abgeben werden.
Das Festival Lollapalooza könnte 2017 auf der Rennbahn Hoppegarten in Brandenburg stattfinden

Sturmtief Axel macht sich nicht nur mit starken Windböen bemerkbar, der Wetterdienst Berlin warnt auch vor starken Gewittern. Anschließend wird es langsam kalt.

Die Jubiläums-Tournee endet für Severin Freund vorzeitig: Der Bayer reist wegen einer Erkrankung vor dem dritten Wettbewerb in Innsbruck ab.
Bislang war der Winter unspektakulär, doch heute ist mit schweren Sturmböen zu rechnen. Vor 30 Jahren herrschte das weiße Chaos

Michael Elmgreen und Ingar Dragset, Kuratoren der Istanbul-Biennale 2017, inszenieren mit „The Others“ eine Schau über die Mitschuld der Kunst an der Unterdrückung von Minderheiten durch Christen.

Jedes Jahr das Gleiche: Das Geböller geht viel zu früh los, es übertönt den Mitternachts-Countdown, das Jahr beginnt ohne klaren Auftakt. Liebe Knallköpfe, könnt ihr nicht pünktlich um zwölf loslärmen?

Fünf Tagesspiegel-Autoren berichten über ihre Interrail-Erlebnisse – fünf Geschichten über Sprachschwierigkeiten, Heimweh und Luxusreisen.

Die jährliche Suche nach Europas bester Vereins-Fußballmannschaft ist die vielleicht reinste Form des europäischen Gedankens – und seine kommerziell erfolgreichste. Ein Lob der Champions League.

„Singin‘ in the Rain“ war ihr großer Durchbruch, danach spielte sie in zahlreichen Musicals und Komödien. Debbie Reynolds war der Star des familientauglichen Entertainments. Ein Nachruf.

Erdogan, Brexit, Flüchtlingskrise: Olli Dittrich brilliert heute wieder in einer TV-Persiflage - in vier verschiedenen Rollen, getarnt als Jahresrückblick.

Erdogan, Brexit, Flüchtlingskrise: Olli Dittrich brilliert heute wieder in einer TV-Persiflage - in vier verschiedenen Rollen, getarnt als Jahresrückblick.

Die Filmwelt ist erschüttert: Hollywood-Schauspielerin Debbie Reynolds hat ihre berühmte Tochter Carrie Fisher nur um einen Tag überlebt.

Die byzantinischen Fresken liefern Informationen, werfen aber auch ganz neue Fragen auf. Eine Randbetrachtung zum Fest der Geburt.

Rasche Erbgut-Entzifferung, hauchdünne Linsen, künstliche Intelligenz: Die Höhepunkte des Wissenschaftsjahres

Viele Millionen Menschen leiden in China unter der hohen Feinstaubbelastung. Nun sind in der Luft dazu noch Spuren von antibiotikaresistenten Bakterien nachgewiesen worden.

Einst war Bad Eilsen die Moorbadewanne West-Berlins, der Kurort in Niedersachsen war Hauptanlaufpunkt für malade Frontstädter. Manche blieben ein paar Wochen, andere für immer. Der vollständige Text - jetzt online.

In Großbritannien ist es nun ausdrücklich erlaubt, Drei-Eltern-Babys auszutragen – wenn es dafür gute Gründe gibt. Eine Zusammenfassung.

Die Post lädt für Montag nach Himmelpfort zur Prämierung der schönsten Wunschzettel. Eine Glosse über einen postalischen Termin beim Weihnachtsmann.
Selten wird in Kirchen allerorten mehr musiziert als in der Advents- und Weihnachtszeit. Vom Kinderchor über die Kantorei bis zum professionellen Ensemble wird meist Altvertrautes, hin und wieder neues Repertoire von einigem Reiz geboten.

Einige Störche haben keine Lust mehr auf den Mega-Flug gen Süden - und überwintern unter anderem in Brandenburg. Der Verzicht auf den langen Flug spart viel Kraft.

Bremen erkämpft sich ein 1:1 gegen Köln, Hamburg verliert nach zuletzt zwei Siegen trotz Führung 1:3 in Mainz. Einen Dämpfer muss Schalke mit einem 1:1 gegen Freiburg hinnehmen. Die Spiele in der Übersicht.

Jetzt fährt die Bahn durch den Gotthard-Basistunnel: Wie die Alpen auf der Reise gen Süden verschwinden.

Als erstes Land weltweit lässt Großbritannien zu, dass Babys mit dem Erbgut dreier Menschen ausgetragen werden - zumindest in klinischen Studien. Die Mitochondrien-Ersatz-Therapie soll schwere Erbleiden verhindern.

Wer das Erbgut verstehen will, muss seine 3-D-Struktur beachten, sagt der Genetiker Daniel Ibrahim.
öffnet in neuem Tab oder Fenster